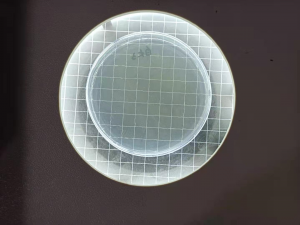

塑料制品材料抗菌检测实验
塑料制品材料抗菌检测实验
1.抗菌
具有杀灭或妨碍细菌或真菌生长繁殖及其活性的作用。
2.实验设备
恒温培养箱,烘箱,高温灭菌锅,电热炉,称量电子天平,振荡器,超净化工作台 ,小型旋涡振荡器,传递窗,紫外灯,菌落计数器,蒸馏水器,电子显微镜。
3.实验材料
聚乙烯薄膜,酒精灯,烧杯,培养皿,试管,试管架,量筒,移液枪,酒精灯,接种环。
4.实验用的标准菌种购买
4.1革兰氏阳性菌 金黄色葡萄球菌ATCC6538
4.2革兰氏阴性菌 大肠杆菌ATCC8739 肺炎克雷伯氏菌ATCC4352
4.3酵母菌 白色念珠菌ATCC10231

注:根据产品的使用要求,可选用其他菌种或菌株作为试验用菌,但必须由国际微生物菌种保藏中心或国家相应菌种保藏管理中心提供。
5. 实验程序
5.1对照样品及受检样品的制备 标准规格5×5cm,厚度不大于0.5cm,数量4片以上。
样品预处理
①高温灭菌121℃,20min后紫外灭菌。
②75℃乙醇溶液擦拭表面,5min后用无菌水冲洗,自然干燥,紫外灭菌。
③无菌水冲洗后自然干燥或烘干,紫外灭菌。
注:根据样品特性择其一,以不得影响其抗菌性能和干扰检测结果为适。
5.2聚乙烯薄膜 (覆盖膜)的制备 规格4×4cm,按其表面积减少该覆盖膜尺寸,以使菌悬液不溢出为适。 75℃乙醇溶液浸泡,5min后用无菌水冲洗,自然干燥,紫外灭菌 。
6.实验的培养基及试剂制备
用于菌液和试验样本的稀释:营养肉汤培养基,蒸馏水,吐温80,氯化钠,含0.1%(体积分数磷酸盐缓冲液),SCDLP液体培养基。
用于金黄色葡萄球菌和大肠杆菌,肺炎克雷白氏菌的培养·: 营养琼脂。
用于培养白色念珠菌的培养: 沙氏琼脂培养基。
注:配制后高温灭菌
7.菌种斜面的制备
7.1采购回来的菌种进行划线平板,置恒温培养箱培样24~48小时 7.2经过培养后制备菌悬液

8.菌液的接种
将对照样品和受检样品分别放入灭菌平皿中,吸取菌悬液分别滴加在其表面上,用镊子夹起覆盖膜平铺在上面,使菌液均匀接触样品,每个样品,每个菌,分别各做3个平行样。在37℃,相对湿度90%下培养16~24小时。
9.稀释
经接触培养后的样品,分别加入一定量的稀释溶液反复洗脱3次以上的样品及覆盖膜,摇匀适当成倍稀释,每样液平行接种2个皿,倾注培养基,待凝固后翻转。
10.培养计数 置37℃培养箱培养24~48小时后活菌计数。一般情况下,做个测试时间是4-6天,但是检测机构是7-10工作日

- 上一条防霉抗菌检测微生物知识有哪些
- 下一条不同塑料抗菌剂的添加流程

